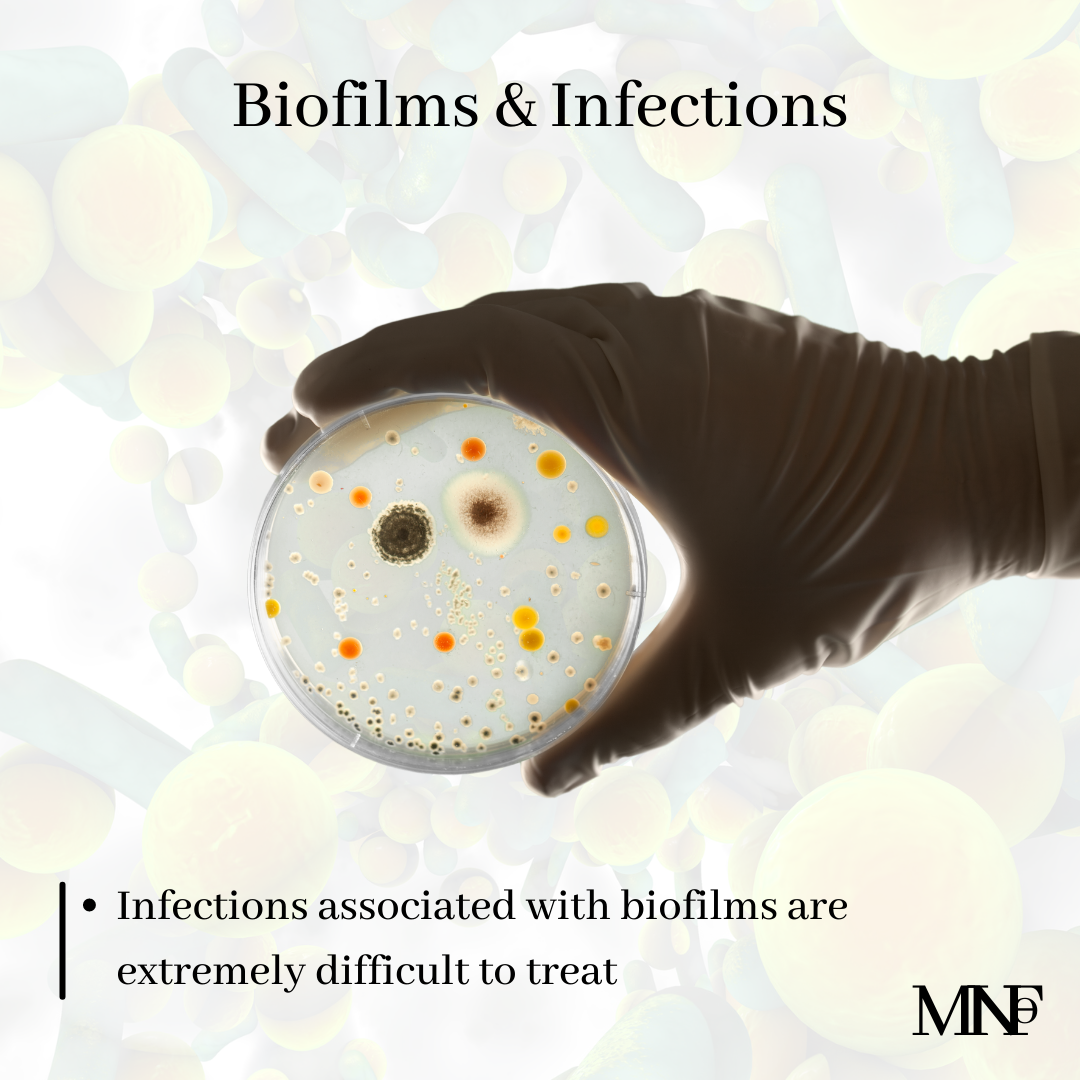

[vc_row][vc_column]
[ultimate_spacer height=”20″][ultimate_heading main_heading=”What is a Biofilm?” heading_tag=”h3″ alignment=”left” margin_design_tab_text=””]Biofilm is a highly organized complex of microorganisms embedded in a matrix. Biofilms form on surfaces when free floating microorganisms settle and start forming colonies. Maturation of biofilm is related to matrix formation. The matrix protects the microorganisms and helps them grow. It consists of carbohydrates, water, lipids, proteins etc. Biofilms even have a system of microbial communication called quorum sensing.
Biofilms can be found in the environment, water systems, humans and animals. In fact, they play an important role in chronic wound infections, infections of respiratory tract, oral diseases etc. Infections associated with biofilms are extremely difficult to treat.[/ultimate_heading][ultimate_spacer height=”20″][/vc_column][/vc_row][vc_row][vc_column][vc_toggle title=”References”]
Significance of biofilms in dentistry[/vc_toggle][/vc_column][/vc_row]